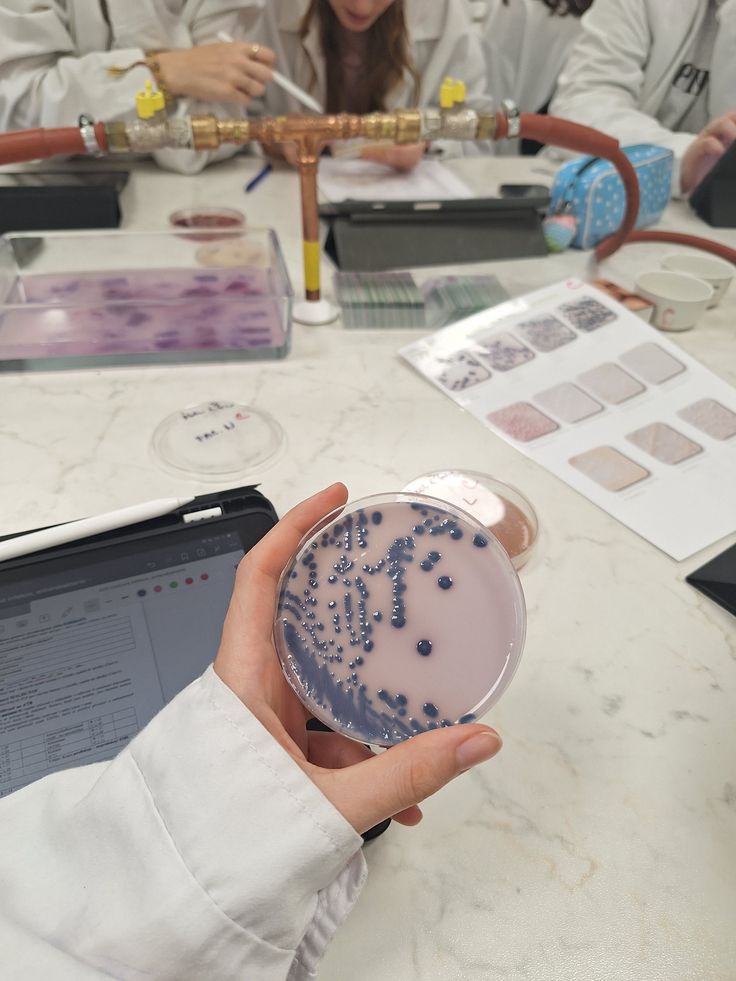

Postgraduate Programmes
Dean's Speech
 It is a privilege to be a part of the family of forward-looking people of the Precious Cornerstone University. This University is positioned to provide quality education which will develop individuals with quest for knowledge and to develop man power at the postgraduate level to cater for the academic and industrial need of our country. The need for cutting edge research that develops solution to problems of the 21st century which are necessary for a developing society like ours, propelled our passion to develop this robust postgraduate programs.
It is a privilege to be a part of the family of forward-looking people of the Precious Cornerstone University. This University is positioned to provide quality education which will develop individuals with quest for knowledge and to develop man power at the postgraduate level to cater for the academic and industrial need of our country. The need for cutting edge research that develops solution to problems of the 21st century which are necessary for a developing society like ours, propelled our passion to develop this robust postgraduate programs.
I want to warmly congratulate you that you have been offered admission into our prestigious postgraduate program. This life-transforming experience will bring the very best out of you. The PCU is a place where you will have contact with refined teachers and researchers with world class finesse. No doubt, this will be a different experience from what you had as an undergraduate student. As you start and chart a new path in life, there will be challenges from our seasoned Lecturers and researchers, this is to bring the best out of you and to make you a total person.
Moreover, you are regarded as a mature student that should be guided and not pampered, the knowledge that you will receive will enable you to be an independent thinker, developed to think out of the box, a problem solver that will form the pillars or pivot upon which the society rests.
Our environment is conducive for learning and allows original thinking. The Postgraduate School is located at the Olubadan Estate, a serene, quiet and peaceful environment with all-inclusive chalets accommodation for adult students. Our Library, Laboratories, studios, internet facilities are such that supports you to accomplish your academic expectation at record time. At the point of admission, supervisors are allocated to students and the arrangements is such that, flexibilities are considered which will enable you to have good interactions with supervisors. Modern methods of teaching and learning are applied at the PCU postgraduate school, students are expected to present seminars to peers and supervisors alike. As much as possible, research students are encouraged to attend conferences (local or international) at least once and are expected to make presentations orally or via postal.
It is my believe that you are going to have a rewarding and fruitful time as a postgraduate student of the Precious Cornerstone University. I wish you the very best.
Professor James Adeyemo Adegoke
(Dean of Postgraduate School)
Our Mission
Precious Cornerstone University is positioned to provide quality education which will develop individuals with quest for knowledge and to develop man power at the postgraduate level to cater for the academic and industrial need of our country. The need for cutting edge research that develops solution to problems of the 21st century which are necessary for a developing society like ours, propelled our passion to develop this robust postgraduate programs.
Accredited Postgraduate Courses
Accounting
Microbiology


